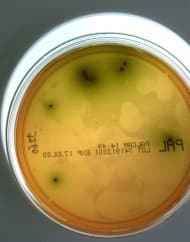

Les autorités sanitaires françaises ont signalé douze cas de listériose, dont deux mortels, en lien avec des charcuteries produites par l’entreprise Drôme Ardèche Tradition, située à Bourg-de-Péage, dans la Drôme. Ce bilan, qui a été annoncé jeudi, concerne des patients ayant consommé des produits de cette entreprise entre septembre de l’année dernière et janvier de cette année.
EN BREF
- Douze cas de listériose recensés, dont deux décès de patients de plus de 75 ans.
- Retrait et rappel des produits concernés, sous supervision des services de l’État.
- Les patients touchés sont majoritairement âgés de plus de 65 ans.
Les enquêtes menées par les services de l’État ont révélé que sept des cas diagnostiqués étaient survenus en janvier. L’âge médian des patients concernés s’élève à 81 ans. Les deux décès signalés sont intervenus chez des personnes de plus de 75 ans présentant des comorbidités, ce qui souligne la vulnérabilité de cette population face à l’infection.
Les produits incriminés comprennent des caillettes, des pâtés en croûte et d’autres charcuteries cuites, commercialisés sous les marques « Drôme salaisons » et « Jules Courtial », entre le 17 janvier et le 28 février. Afin de prévenir toute nouvelle contamination, un arrêté préfectoral a été émis, suspendant l’activité de l’entreprise, qui a également procédé au retrait de tous les produits fabriqués sur son site.
La listériose est causée par la bactérie Listeria monocytogenes, qui représente la seconde cause de mortalité liée aux intoxications alimentaires en France, après les salmonelles. L’infection se manifeste souvent par des symptômes tels que la fièvre, des maux de tête et des courbatures, notamment chez les personnes présentant un système immunitaire affaibli. Les femmes enceintes sont particulièrement à risque, avec une probabilité accrue d’infection, pouvant atteindre jusqu’à vingt fois celle de la population générale.
Les autorités sanitaires ont mis en garde les consommateurs qui pourraient détenir ces produits, leur conseillant de ne pas les consommer. En cas de symptômes évoqués, il est recommandé de consulter un médecin en mentionnant la consommation des produits concernés.
La période d’incubation pour la listériose peut varier de quelques jours à presque trois mois, ce qui complique la traçabilité des cas. Les prélèvements effectués ont confirmé la présence d’une souche de la bactérie dans des produits de l’entreprise, établissant ainsi un lien direct entre la consommation de ces charcuteries et les cas de listériose signalés.
Il est à noter qu’en été 2025, un autre incident lié à la listériose avait déjà suscité l’inquiétude, avec des rappels massifs de fromages associés à des cas similaires. Ces événements soulignent l’importance de la vigilance en matière de sécurité alimentaire et l’efficacité des mesures de contrôle sanitaire pour protéger la santé publique.
Dans ce contexte, les autorités sanitaires continuent de suivre de près la situation et renforcent leurs actions de prévention. Une communication claire et rapide est essentielle pour éviter d’autres cas et rassurer la population sur les risques liés à la consommation de certains produits alimentaires.